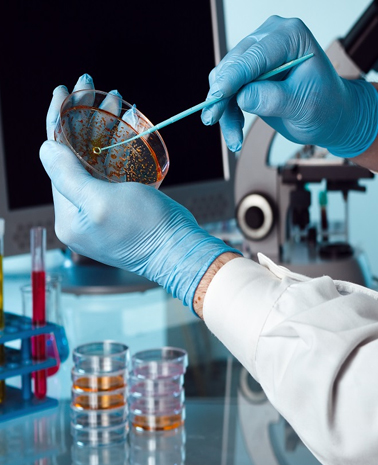

The 6th International Conference on Pharmacy and Toxicology (KSAPT) 2025
KSAPT take place from October 27th to 29th, 2025, at the Narcissus The Royal Hotel. The conference will be held under the umbrella of the Global Forensics Excellence Summit (GFEX), which is a leading global event in the healthcare sector. This conference, organized by the Saudi Pharmacy Association (SPS) in collaboration with the Ministry of Health, will bring together professionals, researchers, and experts from across the Gulf region, the Arab world, and internationally.

0+
Visionary Speakers0+
Worldwide Brands0+
Sessions & Workshops0+
Event Participants
KSAPT Themes
KSAPT 2025 will feature a variety of informative sessions, with expert speakers addressing the most current research, technological innovations, and public health issues in pharmacy and toxicology. The following sessions will be key highlights:

Keynote Speakers’ Session

Genetic Pioneering Areas in Pharmacy and Toxicology

Forensic Pharmacy : Ensuring the Integrity of Medical and Pharmaceutical Practice

Key Insights on Doping Drugs, and Emerging Drugs of Abuse (DOA)

Non-Conventional Medical Threats : Navigating Risks in Healthcare

Digital Transformation in Pharmacology and Toxicology
Competitions
The Prestigious Ksapt 2025 Brings Together Thought Leaders, Researchers, Academics, Professionals, And Emerging Stars In Different Disciplines Of Toxicology And Pharmacy.
Speakers List

Dr. Maram Al-Otaiby
Executive Director, Supportive Health Services Center, Ministry of Health

Dr. Maha Almazroua
President of the 6th International Conference of Pharmacy and Toxicology (KSAPT 2025)

Prof. Ornella Corazza
Professor, Addiction Science, University of Hertfordshire

Dr. Ibrahim S. Alhamod
Doctor of Pharmacy (PharmD), Residency and Fellowship in Ambulatory Care and Cardiovascular Pharmacotherapy

Dr. Ahmed Albassam
Ph.D. in Clinical Pharmaceutical science

Dr.Hassan Gonium
Associate Professor

Dr. Tamer Mohammed Shahata
Ph.D of Pharmaceutics and Industrial Pharmacy

Dr. Ahmed Alnaim
Assistant Professor

Dr.Abdullah Mosa Alhammad
Associate Professor; Manager of Clinical Pharmacy Services and Drug Poisoning and Information Center

Dr. Mansour Alotibi
Assistant Professor

Dr. Hadil Al Muhisen
Toxicologist / Study Director

Dr.Suha Alfehaid
Forensic medicine consultant

Dr. Abdulaziz Almulhim
Associate Professor and Dean

Dr. Maneera Al-Jaber
Laboratory Director and Qatar APMU Director

Dr Ali Alaseem
Chairperson, Associate Professor of Pharmacology

Dr. Mohammed Albikiri
Assistant Professor

Dr. Dania A Hussein
Head of the Department of Pharmacology, Assistant Professor

Dr. Nadiya Alblsuoshi
Assistant Professor

Dr. Heba Elsewedy
Assistant professor

Dr. Mohammed Aldholmi
Assistant Professor

Dr. Khalifa Alrajeh
Assistant Professor

Dr. Ghareeb Omar Alshuwaier
Head of Exercise Physiology Department

Dr. Rashed Almuqbil
Vice Dean of DSR for Research and Innovation

Dr. Ahmed Alasmari
Senior Toxicology Scienist

Dr. Maged ElSayed
Professor

Dr. Hany Ezzat
Associate professor

Dr. Sahar Issa
MBBCh, MSc, PhD, MD Forensic Medicine & Clinical Toxicology

Dr. Monther Alsultan
Assistant Professor

Prof. Mohammed Al-Maadheed
Chairman, Board of Trustees, Anti-Doping Laboratory Qatar

Dr. Nasser Alqahtani
Deputy Minister, Ministry of Human Resources and Social Development

Prof. Dina A. Shokry
Professor of Forensic Medicine and Clinical Toxicology, Faculty of Medicine, Cairo University

Dr. Saeed Alsraiha
Consultant, National Committee for Narcotics Control

Dr. Helal Hetta
Associate Professor of Microbiology,Immunology and Biotechnology

Prof. Mostafa Sarhan
Assistant professor

Dr. Waad Samman
Ph.D. in Molecular Medicine and Pharmacogenetics, Associate Professor of Pharmacology

Dr. Ali Alghubayshi
Assistant Professor

Dr. Khalifa Alrajeh
Assistant Professor

Dr. Mohammed Aldholmi
Assistant Professor

Dr. Heba Elsewedy
Assistant professor

Dr. Nadiya Alblsuoshi
Assistant Professor

Dr. Dania A Hussein
Head of the Department of Pharmacology, Assistant Professor

Dr. Mohammed Albikiri
Assistant Professor

Dr Ali Alaseem
Chairperson, Associate Professor of Pharmacology

Dr. Maneera Al-Jaber
Laboratory Director and Qatar APMU Director

Dr. Abdulaziz Almulhim
Associate Professor and Dean

Dr.Suha Alfehaid
Forensic medicine consultant

Dr. Hadil Al Muhisen
Toxicologist / Study Director

Dr. Mansour Alotibi
Assistant Professor

Dr. Ali Alghubayshi
Assistant Professor

Dr. Waad Samman
Ph.D. in Molecular Medicine and Pharmacogenetics, Associate Professor of Pharmacology

Prof. Mostafa Sarhan
Assistant professor

Dr. Helal Hetta
Associate Professor of Microbiology,Immunology and Biotechnology

Dr. Saeed Alsraiha
Consultant, National Committee for Narcotics Control

Prof. Dina A. Shokry
Professor of Forensic Medicine and Clinical Toxicology, Faculty of Medicine, Cairo University

Dr. Nasser Alqahtani
Deputy Minister, Ministry of Human Resources and Social Development

Prof. Mohammed Al-Maadheed
Chairman, Board of Trustees, Anti-Doping Laboratory Qatar

Dr. Monther Alsultan
Assistant Professor

Dr. Sahar Issa
MBBCh, MSc, PhD, MD Forensic Medicine & Clinical Toxicology

Dr. Hany Ezzat
Associate professor

Dr. Maged ElSayed
Professor

Dr. Ahmed Alasmari
Senior Toxicology Scienist

Dr. Rashed Almuqbil
Vice Dean of DSR for Research and Innovation

Dr. Ghareeb Omar Alshuwaier
Head of Exercise Physiology Department

Dr.Abdullah Mosa Alhammad
Associate Professor; Manager of Clinical Pharmacy Services and Drug Poisoning and Information Center

Dr. Ahmed Alnaim
Assistant Professor

Dr. Tamer Mohammed Shahata
Ph.D of Pharmaceutics and Industrial Pharmacy

Dr.Hassan Gonium
Associate Professor

Dr. Ahmed Albassam
Ph.D. in Clinical Pharmaceutical science

Dr. Ibrahim S. Alhamod
Doctor of Pharmacy (PharmD), Residency and Fellowship in Ambulatory Care and Cardiovascular Pharmacotherapy

Prof. Ornella Corazza
Professor, Addiction Science, University of Hertfordshire

Dr. Maram Al-Otaiby
Executive Director, Supportive Health Services Center, Ministry of Health



WE ARE LOOKING TO MEET YOU AT RIYADH
Join Us in Riyadh – Where Heritage Meets Innovation
Experience the fragrance of tradition and the brilliance of modernity.
























